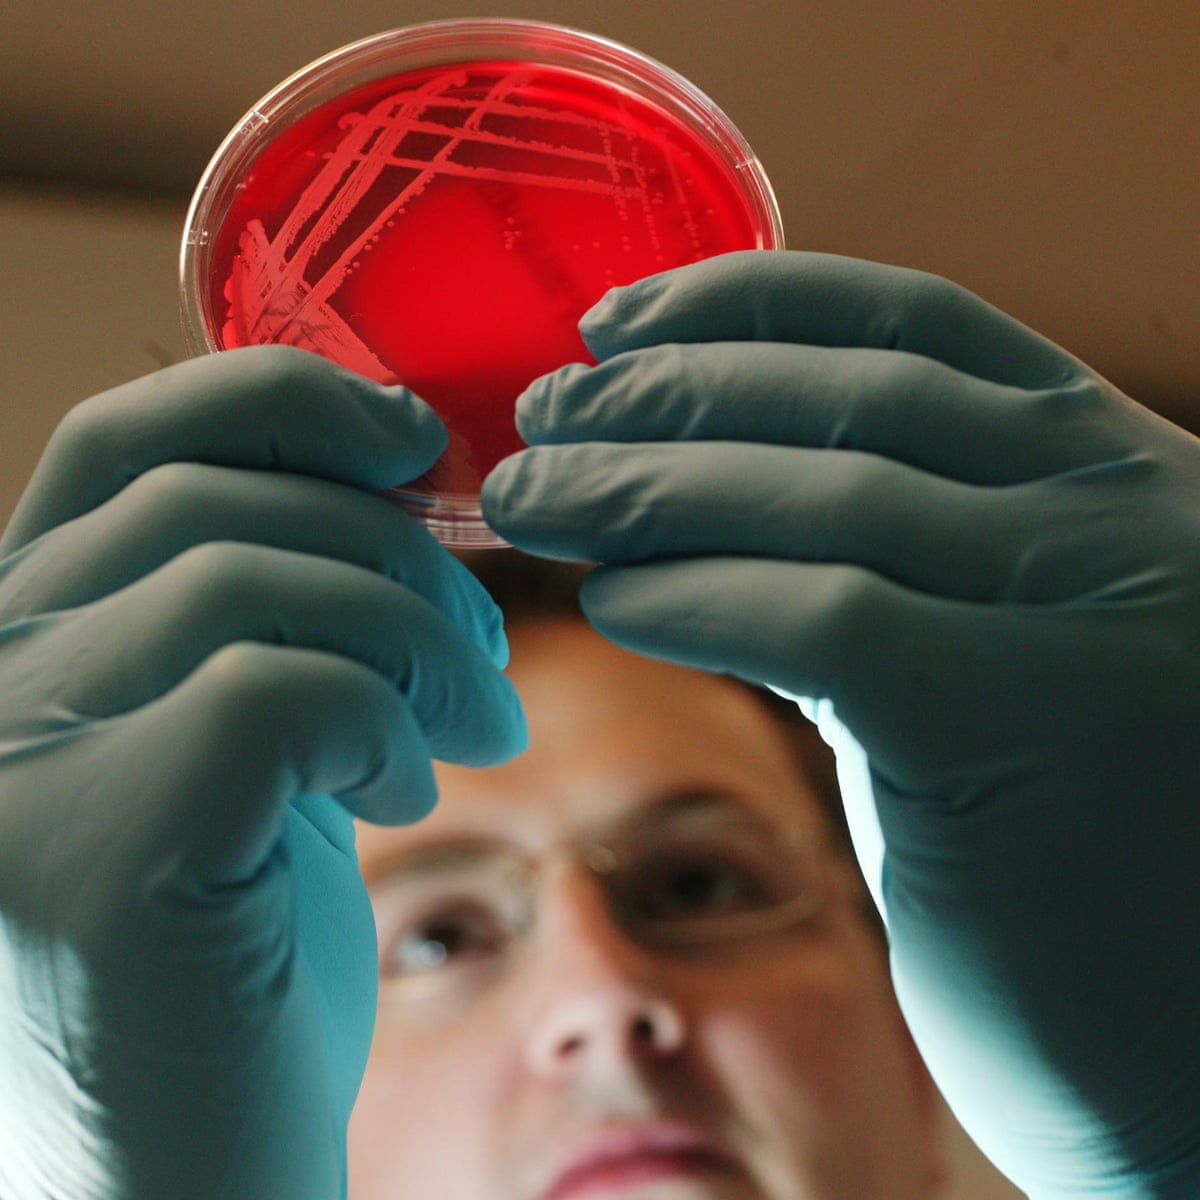

Covid 19 Vaccine Trials Uk - Covid-19 Realtime Info
The phase i trial in healthy adult volunteers began in april.

Covid 19 vaccine trials uk. Our vaccine work is progressing quickly. Please use the links below to access information about how to participate at your local study site. Be told about the research study. The main objectives of the trial including whether the vaccine can prevent covid 19 disease will be reported at a later date.
Imperial college london is advancing the development of an effective covid 19 vaccine. More than 1000 immunisations have been completed and follow up is currently ongoing. At these visits youll usually. We are now recruiting more participants for the first phase of our covid 19 vaccine trial at our west london study facility.
The nhs covid 19 vaccine research registry enables people across the uk to sign up to participate in covid 19 vaccine trials. Whats involved in vaccine studies. Teresa lambe dr sandy douglas prof. Over 100000 people have signed up for future covid 19 vaccine clinical trials through the nhs covid 19 vaccine research registry volunteers are helping speed up efforts to find a safe and.
The purpose of this study is to test a new vaccine against covid 19 in healthy volunteers. Covid 19 vaccine study cov002 what is the purpose of this trial. As requested by the who please ensure that the who official acronym for the coronavirus disease covid 19 is entered in the title field of the trial registration data set annex 1 xml. The team who started work on developing a vaccine to prevent covid 19 on 20th january 2020 is led by prof.
If you take part in a vaccine study you may or may not be offered the vaccine. The trial 1077 participants have been recruited across multiple study sites in oxford southampton london and bristol. Covid 19 phase iiiii vaccine study cov002 this trial is being conducted across multiple locations in the uk. The oxford vaccine centres covid 19 vaccine trial is being run by the jenner institute and oxford vaccine group.
The service was commissioned by the uk governments vaccine taskforce in partnership with nhs digital the national institute for health research nihr and the northern ireland scottish and welsh governments. Youll need to visit the hospital or other research site a few times over 6 to 12 months. Catherine green and prof.